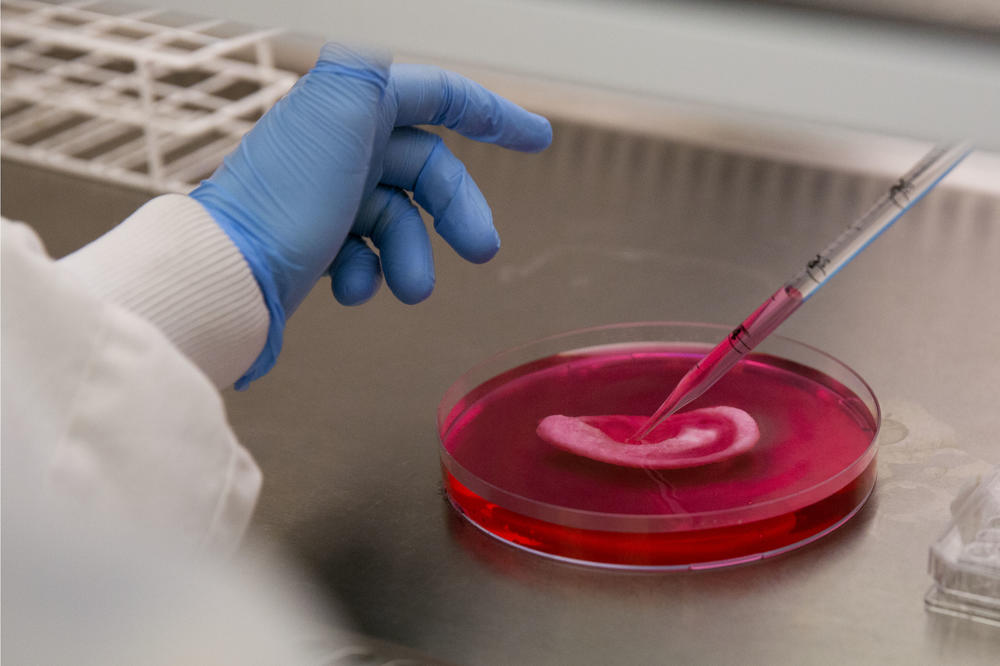
12 KRIVACA ZBOG KOJIH VAM HOLESTEROL NENORMALNO RASTE: Na većinu ne biste NI POMISLILI

OBRATITE PAŽNJU
12 KRIVACA ZBOG KOJIH VAM HOLESTEROL NENORMALNO RASTE: Na većinu ne biste NI POMISLILI
I pored promene stila života, ponekad je nemoguće održavati nivo HDL i LDL holesterola u granicama normale
Ukoliko patite od povišenog holesterola, znate koliko je važno da steknete naviku da se zdravo hranite i da održavate fizičku kondiciju.
Promena životnih navika može da pomogne u snižavanju lipoproteina niske gustine (LDL ili „lošeg“ holesterola) i triglicerida, oblika masti koja se nalazi u krvi, kao i u povećanju nivoa lipoproteina velike gustine (HDL ili „dobrog“ holesterola).
U procesu snižavanja povišenih vrednosti holesterola, važno je pridržavati se četiri pravila - biti redovno fizički aktivan, voditi računa o ishrani, izbegavati konzumiranje duvana i održavati zdravu telesnu težinu.
Premda su ove promene načina života veoma važne za pomoć u regulisanju visokog holesterola, one nisu uvek dovoljne za sve. Postoje “krivci” koji podrivaju sve vaše napore, piše eKlinika portal.
1. Loša genetika
Ako imate relativno zdrav način života i vaš nivo holesterola je visok, imate LDL veći od 160, verovatno imate neku genetsku komponentu koja dovodi do visokog holesterola – kaže kardiolog dr Raj Khandwalla.
Porodična hiperholesterolemija (FH) je nasledno stanje koje dovodi do nakupljanja holesterola u krvotoku. Kada dobijete dijagnozu visokog holesterola, vaš lekar može da vam prepiše statin, vrstu leka koji blokira supstancu koju vaše telo koristi za stvaranje holesterola.
– Statini pomažu u snižavanju LDL holesterola, što smanjuje rizik od moždanog udara ili smrti od srčanog udara – kaže dr Khandwalla.
2. Niste odabrali adekvatnu dijetu
Dr Khandwalla naglašava da bi ljudi koji imaju visok holesterol trebalo da izbegavaju keto dijetu, dijetu s visokim udelom masti, s malo ugljenih hidrata, koja se reklamira kao odlilčna za gubitak težine. Preopterećenje ishrane mesom može povećati unos zasićenih masti, što može povećati nivo holesterola.
– Najefikasnije dijete za snižavanje holesterola su biljna ishrana ili veganska ishrana u kojoj smanjujete unos holesterola – kaže dr Khandwalla.
Ukoliko, pak, želite da uključite meso u ishranu, držite se nemasnih proteina, poput piletine, ćuretine i ribe.
3. Ne obraćate pažnju na skrivene masti u ishrani

Da bi nivo holesterola u krvi bio u granicama normale, važno je ograničiti ne samo zasićene masti, već i trans masti koje povećavaju LDL.
Izbacite nezdrave masti tako što ćete jesti manje crvenog i prerađenog mesa (poput kobasica), manje putera i punomasnih mlečnih proizvoda.
4. Zdrava ishrana nije dovoljna
Iako je zdrava ishrana od suštinskog značaja, ona nekada možda neće biti dovoljna ako ste genetski predisponirani na visok holesterol.
– Sa promenama u ishrani, možete očekivati smanjenje od 5 do 10 odsto u tome koliko mogu smanjiti vaš holesterol, ali rezultati su promenljivi - kaže dr Ray Khandwalla.
Prema njegovim rečima, od pomoći mogu da budu vežbe, ali i lekovi.
5. Jedete gotovu hranu
Kuvajte, kuvajte, kuvajte! Kada sami pripremate hranu, znate šta ste uneli u organizam.
Kad neko to čini umesto vas, rizikujete da pojedete sastojke koje inače izbegavate.
6. Ne vežbate pravilno
Iako je svaka fizička aktivnost dobra, aerobne ili kardiovaskularne vežbe dokazano pomažu u snižavanju LDL i povećanju HDL.
Zato bi bilo dobro da razmislite o hodanju, vožnji bicikla, plivanju, plesu ili drugim kardio aktivnostima koje možete raditi umerenim intenzitetom.
7. Uzimate lekove koji povećavaju holesterol
Pojedini lekovi poput steroida, retinoida i progestina mogu da utiču na povećanje nivoa holesterola.
Zbog toga vaš lekar mora da zna koje sve lekove uzimate. Jer, postoje alternativni tretmani koji neće uticati na vaš holesterol.
8. Pijete previše alkohola
Ukoliko ste ljubitelj alkohola, potrudite se da ga unosite u umerenim količinama ako već ne možete da ga se odreknete.
Previše alkohola može da poveća holesterol i trigliceride, kao i telesnu težinu. Preporuka je da muškarci ne piju više od dva pića dnevno, a žene jedno.
9. Ne uzimate statine kako je propisano

Statini su imali ogroman uticaj na spasavanje života. Ali, da bi bili efikasni, moraju se uzeti tačno onako kako je propisano.
Pobrinite se da znate kada ih uzimate i u kojoj dozi, a farmaceuti mogu da odgovore na sva vaša pitanja.
10. Statini nisu dovoljno efikasni za vas
Postoji podgrupa ljudi koji nisu u stanju da tolerišu statinske lekove. Pacijentima koji su već imali srčanu bolest ili moždani udar može se dodati i ezetimib.
Postoji još jedna klasa lekova koja se takođe može koristiti za snižavanje LDL, koja se naziva inhibitor PCSK9, ali se generalno preporučuje samo kod pacijenata sa vrlo visokim rizikom od srčanog ili moždanog udara.
11. Imate nerealna očekivanja
Ukoliko ste nedavno promenili način života ili počeli da uzimate lekove, možda je prerano da očekujete dobre rezultate.
Kao što niste razvili visok holesterol "preko noći", tako ga nećete ni vratiti u normalu "preko noći". Budite uporni i strljivi.
12. Oslanjate se na terapiju i ne menjate stil života
Studija objavljena u februaru 2020. u časopisu Američkog udruženja za srce otkrila je da ljudi sa visokim holesterolom imaju tendenciju da dobiju više na težini i da manje vežbaju kada počnu da piju statine.
Uprkos tome što su statini i drugi lekovi za snižavanje holesterola veoma efikasni, nije zamišljeno da oni budu jedini način za regulisanje visokog holesterola. Ukoliko vam je potrebna pomoć oko promene načina života, potražite savete stručnjaka za ishranu.
(Espreso/ Telegraf)
Uz Espreso aplikaciju nijedna druga vam neće trebati. Instalirajte i proverite zašto!







